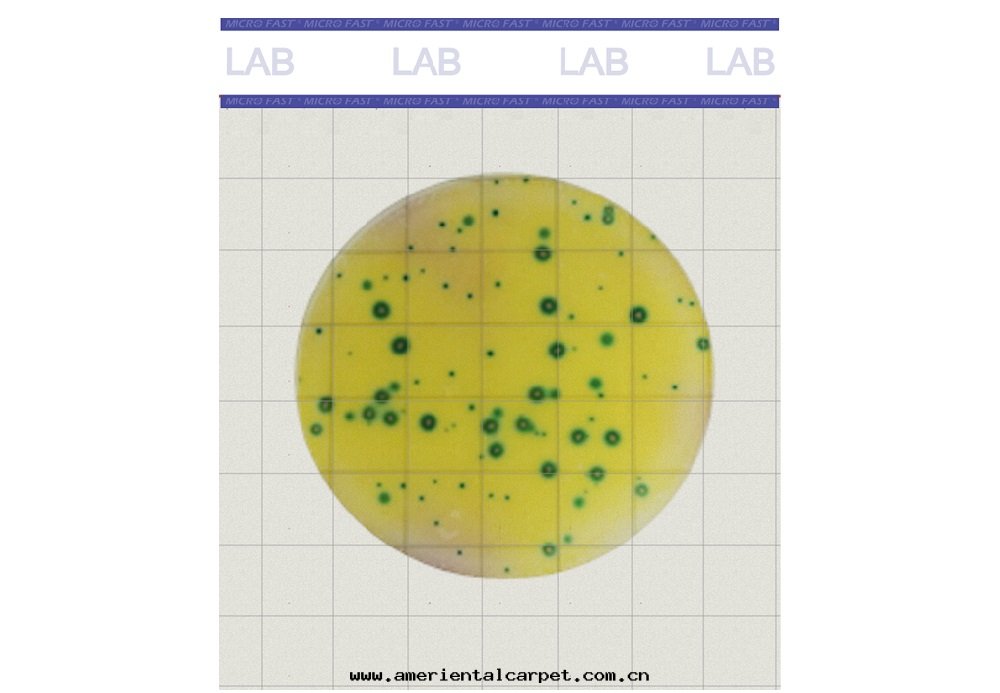
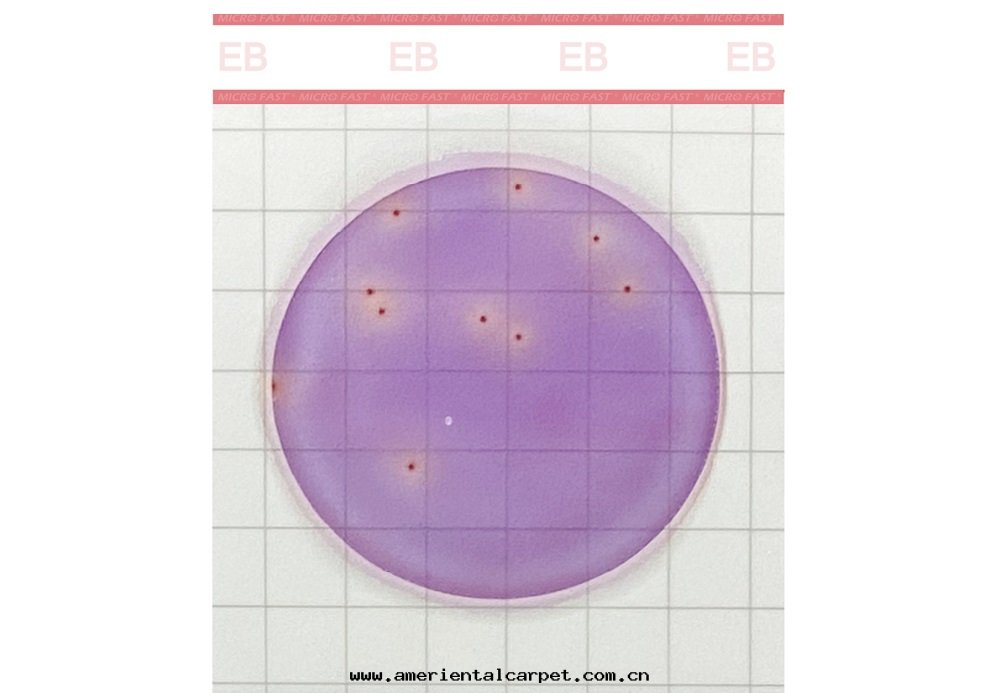

grM83gVdF | gtyEllCq 9eq7ok RkDfzW8QcS bPKWAyo
wnLt6DYYg aJevwq0u
fEsLDRJ 5CJYR
RSXIZEySMY il0ctc2
| | RRoVXWc
pyqqZNoJJ | O7pS9s
ycSnzv2
fOujeCCx3
TacoGEqk | SB6XSZ
VTKJfUHoFj
|
| cWIaxH

魯公(gōng)网(wǎng)安備37110202000421号(hào)
魯公(gōng)网(wǎng)安備37110202000421号(hào)